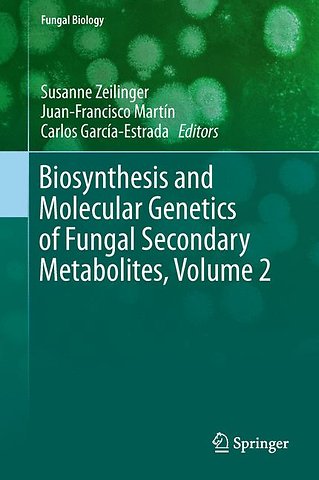

Biosynthesis and Molecular Genetics of Fungal Secondary Metabolites, Volume 2
Samenvatting
Fungi produce many chemically diverse secondary metabolites whose biological roles largely remain elusive. Within the increasing number of sequenced fungal genomes several important genes involved in secondary metabolite formation have been identified. Most of these genes are clustered and their coordinated transcription is controlled in a complex way by both narrow pathway-specific regulators as well as broad global transcription factors responsive to environmental cues. In recent years it was discovered many of the newly identified gene clusters are silent under laboratory conditions suggesting that the biosynthetic potential of fungi is far from being exploited. Besides identifying novel bioactive metabolites from still unexplored sources, the activation of these gene clusters by several approaches may result in the discovery of new substances with antibiotic and pharmaceutical benefits. This book covers recent advances in the field of fungal secondary metabolisms ranging from methodologies to biological aspects and will include the latest knowledge on fungal molecular biology, genomics, and metabolomics. With the related volume by Professor Juan-Francisco Martin, where the most relevant and well-studied fungal secondary metabolites are compiled, this book provides a comprehensive overview of the state-of-the-art of research on fungal secondary metabolites.